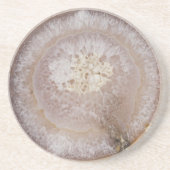
Beaux dessous de verre d'agate (Devant)

A propos de Dessous de verres
Vendu (e) par
À propos de ce design
Les parties en pierre d'agate sont simulées par le design. Il n'y aura pas une réelle pierre d'agate sur ce produit.
Beaux dessous de verre d'agate
Des dessous de verre renversants d'agate qui sembleront extraordinaires dans votre maison !
Traduction automatique
Avis des clients
Aucun commentaires sur ce produit pour le momentAvez-vous acheté ce produit ?
Tags
Autres infos
Identifiant du produit : 174619548210958356
Fabriqué le 02/09/2015 17:37
Évalué G
Articles vus récemment